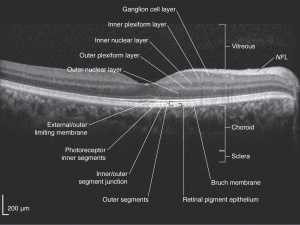

Use of OCT in Neurodegenerative Diseases
All content on Eyewiki is protected by copyright law and the Terms of Service. This content may not be reproduced, copied, or put into any artificial intelligence program, including large language and generative AI models, without permission from the Academy.
Introduction
Neurodegenerative diseases (NDDs) are devastating disorders which impair memory, cognition, movements, and general functioning. Although these diseases have distinctive patterns of signs and symptoms, they share many common features:
- A strong association with age
- Aberrant protein aggregation
- A slow, relentless natural history[1]
This group of diseases is also characterized by an insidious onset in which neuropathological changes develop years before clinical presentation.[2]
NDDs are often difficult to diagnose in early stages due to heterogeneity of their initial presentation, the evolving nature of their course, and overlap with other neurologic conditions, and normal aging. This delays not only accurate diagnosis, but also initiation of treatment. Sadly, the clinical picture is often ambiguous until the disease is advanced and a significant amount of neuronal tissue has been irreversibly lost. The examples of NDDs include:
- Alzheimer’s disease (AD)
- Parkinson’s disease (PD)
- Amyotrophic Lateral Sclerosis (ALS)/Motor neuron disease (MND)
- Huntington's disease
- Frontotemporal dementia
The retina is an extension of the central nervous system, and it is the only portion that can be viewed non-invasively. It stands to reason, therefore, that neurodegenerative disorders might also cause degeneration of neurons in the retina. Postmortem tissue studies have corroborated this hypothesis, showing loss of tissue thickness in Alzheimer’s disease (AD)[3] [4] [5], Parkinson’s disease (PD)[6], and Amyotrophic Lateral Sclerosis (ALS).[7] [8] However, whether this loss of tissue represents primary neurodegeneration within the retina itself or instead secondary retrograde degeneration due to neuronal and axonal loss in the brain has not yet been determined.
Optical coherence tomography (OCT) is a non-invasive imaging technique which uses reflected light to create high resolution, two or three dimensional representation of retinal architecture. Measurement of the various retinal layers allows for objective, quantitative assessment of structural damage in the visual pathway.[9] OCT has therefore emerged as a non-invasive and relatively inexpensive technique for capturing loss of central nervous system axons and neurons. Because of these advantages, OCT is now being explored as a potential tool to identify retinal changes in patients early in the course of NDDs, and to allow quantifiable, objective monitoring of axonal and neuronal loss with disease progression.
For a video explanation of OCT imaging click here: https://www.aao.org/clinical-video/basic-principles-of-oct
OCT can identify changes in thickness within specific quadrants of the retina. Abnormalities in particular quadrants or combinations of quadrants may indicate a certain pathology and aid in distinguishing similar diseases or disease progressions.
More recently, a subset of OCT, the OCT Angiography is a modality that images integrity of the vasculature in the retina and optic nerve mainly assessing the blood perfusion.[10] It has already described abnormalities in Parkinson’s disease, Huntington’s disease, amyotrophic lateral sclerosis (ALS), Alzheimer's disease, and multiple sclerosis among others(Table 1). However, significant OCT Angiography studies still haven’t fully characterized the expected changes in some conditions, such as amyotrophic lateral sclerosis (ALS) and Huntington’s disease. Despite the lack of current studies, OCT Angiography is projected to be a useful tool for evaluating neurodegenerative diseases[11]

Alzheimer’s Disease (AD)
Background
Alzheimer’s disease (AD) is the most common NDD, affecting an estimated 5 million Americans. This number is expected to rise to 14 million by 2050 as the general population ages.[12] It is characterized by massive neuronal loss in the hippocampus and cortex impairing memory and executive functioning[13], including dysfunction of speech, language, and perception. The pathology of AD is complex but characterized by loss of neurons, brain atrophy, extra-cellular deposition of amyloid Beta (Aβ) plaques, and intracellular accumulation of neurofibrillary tangles composed of phosphorylated tau protein.[14] Symptoms appear very gradually after years of collective neuronal loss.[2] Definite diagnosis formally requires brain biopsy or autopsy confirming the Aβ plaques and neurofibrillary tangles that characterize AD.[13][15] Clinical assessment is imprecise due to heterogeneity of presentation and overlap with other dementing disorders. However, there is evidence that pre-clinical AD (PCA) may be able to be detected in cognitively normal patients using positron emission tomography (PET) of Aβ binding and Aβ and Tau levels in cerebrospinal fluid.[14]
Ophthalmologic findings of AD include visual field deficits, more prominent in the inferior visual fields [16], decreased contrast sensitivity, impaired oculomotor function, and abnormal viewing behavior.[17] [18] [19] Visual dysfunction is common in AD and consists of impairment in spatial contrast sensitivity, motion perception, and color discrimination.[3] [4] [5] Although these deficits have been attributed to damage to the primary visual cortex and visual association areas, there is increasing evidence that cortical dysfunction alone cannot account for all of the visual defects in AD.
Autopsy studies published as early as 1986 revealed retinal abnormalities in patients with advanced AD.[3] [4] [5] Compared to age-matched healthy controls, AD patients were found to have neuronal loss throughout the retina[3], with the most significant decrease in neuronal density in the foveola.[4] Two subsequent reports confirmed these findings using electroretinography, finding retinal ganglion cell (RGC) dysfunction in AD patients.[20] [21] This work was corroborated by experiments using paraphenilene-diamine techniques.[22]
Mild Cognitive Impairment (MCI)
MCI is known as a phase between age-related memory problems(normal "aging") and dementia. Clinically, the symptoms are subjective and of mild cognitive impairment not impacting the daily activities of the patients. MCI may have memory loss, aka amnestic MCI which signifies a higher risk for conversion to dementia[23].
In these cases, OCT may help adjudicating if AD vs MCI. For example, MCI shows pRNFL loss but not more than AD. The interpretation of results depend on the method of comparison used (sectorial vs global). AD affects the GCC-IP complex more than in MCI[23].
OCT Findings
OCT was first used to analyze retinal tissue structure in patients with AD in 2001,[24] and more than two dozen studies exploring its use in this disease have been published since. Studies have consistently reported thinning of the retinal nerve fiber layer (rNFL) compared to age-matched control subjects.[2][18][24][25] [26] Despite this general agreement, there is significant discrepancy in findings related to which quadrant is most severely affected.[2] [24] [26] A meta analysis of case-control, cross sectional studies, or prospective design studies published prior to December 2017 reviewed 30 eligible studies involving 1257 AD subjects and 1460 controls. Comparison of rNFL thickness in those with AD compared with healthy controls found decreased thickness in all retinal quadrants, of which the superior quadrant demonstrated the most significant reduction.[27] For the differences found in OCT, it is important to adjudicate if the OCT variability is influenced by intervisit or intravisit variabilities. In a study by Loh et.al[28], it was confirmed that changes were still present between mild cognitive impairment (MCI) and AD when compared to controls even after intra-inter visit variabilities were taken into account, with decreased average RNFL, superior RNFL quadrant and average ganglion cell layer between MCI and AD when compared to normal controls (approximately 12.40–20.00 µm, 27.10–30.09 µm and 3.42–4.99 µm, respectively).
Use of OCT to evaluate disease severity has proven more difficult. One study by Parisi, et al did not find correlation of thinning with age or mental status exam results,[24] while another by Paquet, et al. has been shown to be more severe in patients with advanced AD compared to those with mild disease.[26] Additionally, a study by Salobrar-García, et al found significant thinning of foveal, inner macular ring, and superior and inferior retinal density in Alzheimer’s patients compared to healthy controls. The study reported increased foveal thickness and inner macular ring thickness in patients with mild disease compared to moderate disease[29], suggesting the utility of OCT for determining disease progression and severity.
La Morgia et al failed to show any correlation between thinning and duration of disease or MMSE (mini-mental state examination) scores.[30] One of the major limitations of these studies is poor characterization of AD cohorts in terms of disease severity, as well as the presence or absence of biomarkers known to be associated with AD. Many use the Mini Mental Status Examination to evaluate disease severity, but it is a fairly crude assessment of cognitive function and provides limited insight into histopathologic changes.
To date, the ability of loss of rNFL and ganglion cells as measured by OCT to differentiate AD patients from control subjects, and the degree to which changes on OCT correlate to severity of AD remain understudied, and OCT may prove a promising candidate as a non-invasive biomarker to help predict future AD.
Parkinson’s Disease
Background
Parkinson’s disease (PD) is the second most common NDD. Patients present with progressive bradykinesia, tremor, rigidity, and postural instability due to loss of dopaminergic neurons in the substantia nigra and brainstem.[31] Symptoms generally appear only after loss of approximately 80% of these neurons.[32] Ophthalmologic complaints include blepharospasm, convergence insufficiency, and dry eye secondary reduced blinking due to alterations in efferent visual pathways. Visual deficits in PD include abnormal color contrast sensitivity, motion perception abnormalities, and impairment of visual acuity, color vision, stereopsis, and pupil reactivity.[33] As with AD, diagnosis is based on a general clinical picture and the elimination of other diagnoses. To date, no biomarker has been identified to confirm the diagnosis, although many new neuroimaging techniques are currently under investigation.[34]
Dopamine is an important neurotransmitter in the retina. Dopaminergic amacrine cells are present in the inner nuclear and inner plexiform layers (INL and IPL). Dopamine receptors have been identified on retinal pigment epithelial cells, photoreceptors, Mueller glial cells, bipolar cells, horizontal cells, and ganglion cells in the retina.[35] Dopamine modulates the receptive fields of the ganglion cell layer (GCL) to provide spatial contrast sensitivity and color vision, and has additional roles in light adaptation and regulation of melatonin production.[36] [37] Post-mortem analysis revealed that eyes from patients with PD have reduced dopamine content compared to age-matched controls.[6]
OCT Findings
Given the importance of dopamine in regulating several visual processes, many studies hypothesized retinal changes in PD. Early reports using time-domain OCTs found general thinning of the rNFL in PD patients, although there was some disagreement as to which quadrant was most severely affected.[32][38] Later studies with SD-OCT technology were less congruent; two reports supported earlier findings in PD patients with both mild[31] and severe[39] disease. Additionally, rNFL thinning was found to correlate with increased disease duration and stage,[40] as was measurement of peripapillary rNFL.[41] However, two reports found no difference in rNFL thickness of PD patients compared to control, although these studies included patients of non-specific disease stage [42]and with a wide range of disease duration.[43] To better evaluate these discrepancies, a meta-analysis of the data published in the last decade concluded that patients with PD have reduced rNFL thickness in all quadrants.[44]
Studies of foveal involvement have also produced controversial results. One small study found an association between foveal thinning and Parkinsonian symptoms.[45] Another group reported no difference in foveal thickness in PD patients with advanced disease compared to controls, but did find asymmetry in foveal thickness between eyes of PD patients.[46] A third study reported both foveal thinning as well as asymmetry in foveal thickness. Interestingly, they also reported that the fovea was often thinnest in the eye contralateral to the limb with most severe parkinsonian symptoms, suggesting that ocular involvement of PD follows the same asymmetrical pattern that is seen elsewhere in the body.[47] Spund et al. reported thinning and broadening of the foveal pit of patients with PD. The authors suggested this change in foveal architecture may provide a “quantifiable signature of PD”.[48] Current studies are underway to mathematically characterize foveal pit changes that may serve as a predictive tool for PD diagnosis and progression.[49]
Examination of individual layers of the retina has also shown conflicting results. The first report by Albrecht et al. using manual segmentation reported increased INL thickness in PD patients compared to age-matched controls.[50] This finding was subsequently confirmed by Garcia-Martin and colleagues using automated logistic regression analysis, although these authors additionally report thinning of the rNFL, GCL, inner plexiform layer (IPL) and outer plexiform layer (OPL) in the same patient population.[40] Using a semi-automated method of differentiating retinal layers, however, Schneider et al. reported no differences in thickness of any retinal layer in PD patients compared to control.[51]
As the inner retinal layer (IRL) ['internal limiting membrane, nerve fiber layer, ganglion cell layer, and inner plexiform layer down to the inner nuclear layer interface'] specifically contains dopaminergic amacrine cells, several studies have examined the relationship of this layer and PD. Adam et al. found IRL thinning in PD patients compared to control.[52] Similarly, a study of paramacular IRL found an approximate 15% decrease in thickness in PD patients compared to age-matched controls.[53] This was hypothesized to be directly due to the loss of dopaminergic cells in PD pathogenesis.[48][52]
Recently, new swept source OCT (SSOCT) technology has confirmed retinal thinning in PD patients, while also showing increased choroidal thickness. The authors suggest choroidal thickening could be a consistent feature of PD, but studies so far are contradicting each other and both suggest possible vascular changes, alterations in perivascular connective tissue density and hypoperfusion.[54]
Zou et al have demonstrated decreases in temporal quadrant RNFL thickness, total macular volume, macular retinal thickness, and ganglion cell-inner plexiform layer complex (GCL-IPL) thickness in the eyes of PD patients when compared against those of healthy, age-matched controls. Further, OCT angiography (OCT-A) data showed decreased vessel length density (VLD) in the central, inner and full regions, vessel perfusion density (VPD) in all regions, and FAZ circularity index in eyes of PD patients.[55]
More work is needed to better understand changes in the retina that occur during PD progression. Although some controversy remains in which specific markers are most useful and most reliable for early detection of PD, the literature largely supports the presence of retinal changes during disease progression that can potentially be used to both diagnose and monitor early disease progression.
Progressive Supranuclear Palsy and Multiple Systems Atrophy
Progressive supranuclear palsy (PSP) and multiple systems atrophy (MSA) are rare variants of NDD. PSP is characterized by degeneration of neurons in the basal ganglia and brainstem, including the substantia nigra. Clinically, patients present with vertical ophthalmoplegia, postural instability, pseudobulbar palsy, mild dementia and parkinsonism unresponsive to levodopa; however, there is wide variation in presentation and significant overlap amongst this sub-group of NDDs, making the diagnosis difficult.[56]
MSA is a sporadic NDD characterized by various degrees of autonomic dysfunction, cerebellar abnormalities, parkinsonism, and corticospinal degeneration. MSA can be further classified into two sub-types, one involving degeneration of nigrostriatal pathways with parkinsonian features. The second primarily involves olivopontocerebellar atrophy and presents with more prominent cerebellar ataxia. Given the diverse clinical features of MSA and significant overlap with PD and PSP, early diagnosis of MSA can be challenging. As in other NDDs, a diagnosis of MSA is presumed until confirmed by post-mortem autopsy with tissue samples showing α-synuclein inclusions in glial cells.[57]
Use of OCT has been explored as a means to better distinguish PSP and MSA, although with conflicting results. Using software based on tensor imaging and fiber tracking software to allow for semi-automated measurement of individual retinal layers, Schneider et al.[51] found retinal changes that were both sensitive and specific to each disease. Patients with PSP were found to have thickening of the OPL[50][51] with relative thinning of the outer nuclear layers ONL compared to controls. The ONL:OPL ratio was found to have a sensitivity of 88% and specificity of 91% in differentiating PSP (<5.03) and MSA (>5.03).[51] Furthermore, patients with MSA had increased thickness of the OPL compared to both healthy control subjects and those with PSP, which may serve as selective marker of this disease.[51]
Recently, spectral domain optical coherence tomography (SD-OCT) has been employed to evaluate retinal thickness in PSP both individually and compared to PD patients. Significant differences were found both compared to age-matched controls and PD patients, so SD-OCT has shown promise as a future diagnostic aid for PSP.[58] [59]
Amyotrophic Lateral Sclerosis
Background
Amyotrophic Lateral Sclerosis (ALS), commonly known as “Lou Gehrig’s Disease”, is a progressive paralyzing disease caused by degeneration of both upper and lower motor neurons in the primary motor cortex, brainstem, and spinal cord.[60] The diagnosis of ALS is one of exclusion as there are no currently known specific biomarkers of the disease; unfortunately, this often results in initial misdiagnosis of a significant number of patients who present early in their disease course with only lower motor neuron signs.[60]
Evidence has suggested as early as the 1960s that the degeneration in ALS may also involve non-motor neurons.[61] [62] This has been investigated using a variety of techniques, including sensory action potentials,[63] [64] [65] [66] nerve biopsy,[63] [64] and MRI imaging of the sensory cortex.[67] These reports confirm the involvement the sensory neurons in up to a third of patients with ALS.[64]
Visual complaints are not frequent in ALS patients, although it is known to affect the oculomotor pathways late in disease progression. Other ophthalmic findings include gaze fixation instability, saccadic abnormalities, supranuclear gaze palsies, and reduced Bell’s phenomenon. A recent cross sectional study found additionally reduced visual acuity in ALS patients.[68] Smaller case studies of familial ALS have also suggested decreased contrast sensitivity[7] and efferent pupillary defect.[8]
OCT Findings
OCT imaging has more recently been used to both explore early diagnosis of ALS as well as to examine involvement of the optic neuron in the degenerative process. Using a generalized estimating equation to determine RNFL thickness, no differences were found between retinas of ALS patients and those from age-matched controls.[69] Additionally, no association between RNFL thickness and disease severity has been found.[69][70] However, a study of patients with familial ALS reported optic nerve pallor with corresponding loss of the papillomacular bundle and thinning of the RNFL on OCT imaging,[71] suggesting that OCT analysis may be useful in at least some subsets of ALS diseases. A 2017 study by Mukherjee et al used SD-OCT to demonstrate retinal thinning in 21 ALS patients who did not have concomitant ocular pathology, suggesting potential use as a diagnostic aid may increase as OCT technology improves.[72]
The discrepancies in findings may be related to the wide variation in underlying pathophysiological mechanisms of ALS as well as the inclusion of patients in different stages of disease progression. Ongoing studies seek to better understand the interplay between specific etiologic factors and ophthalmic manifestations of ALS[70][73] as well as to identify potential biomarkers for more accurate and earlier diagnosis of this disease.[74] [75]
Huntington's Disease
Background
Huntington's disease (HD) is a fully penetrant neurodegenerative disease caused by a dominantly inherited CAG trinucleotide repeat expansion in the huntingtin gene on chromosome 4. Those with greater than 39 CAG repeats are certain to develop the disease, while reduced penetrance is seen between 36 and 39 repeats. HD is characterized by cognitive, motor, and psychiatric disturbances.[76]
HD causes neuronal loss in the brain, especially in the cortex and striatum.[77] Visual features include inability to perform voluntary saccades and fixation and pursuit abnormalities.[78][79] Fewer neuronal connections have been found between the frontal cortex and caudate nucleus in HD patients, and this pathway corresponds to the one used to initiate voluntary saccades.[80]
OCT in Huntington's disease (HD)
There have been varying results for retinal thickness on OCT in HD patients. One paper found that even though the average peripapillary retinal nerve fiber layer in patients was similar to that of the control group, the temporal RNFL was significantly thinner in HD patients (62.3 um vs. the control group at 69.8 um).[81] A second study concurred that there is temporal RNFL thinning in HD patients and also suggested that the superior RNFL could be similarly impacted.[82] A third study did not find either temporal or superior RNFL thinning.[83]
Frontotemporal Dementia
Background
Frontotemporal dementias (FTD) are a heterogeneous group of neurodegenerative disorders characterized by marked impairments in behavior, personality, language, and motor function. FTD is the second most common form of cognitive impairment in those 65 and younger.[84] Patients with FTD commonly demonstrate apathy, disinhibition, social withdrawal, and language impairments. Patients may also exhibit motor symptoms such as muscle atrophy (motor neuron disease), apraxia (corticobasal syndrome), falls, and eye movement abnormalities (progressive supranuclear palsy).[85][86] FTD is pathologically characterized by frontal and temporal lobar atrophy of the brain accompanied by astrocytosis, microgliosis, and the deposition of misfolded proteins, including tau, FUS and TDP-43.6.[84] [87]
OCT Findings
Although there have been very few studies, recent data suggests that outer retinal thinning may be an ocular signature of FTD. Kim et al. reported significant thinning of two outer retinal layers—the outer nuclear layer (ONL) and ellipsoid zone (EZ)—in patients with FTD as compared to subjects without dementia, controlling for age, sex, and race.[88] In a follow-up study investigating the relationship between the rate of change of retinal thickness and progression of FTD, Kim et al. reported an association between interval reductions in outer retinal thickness and cognitive decline quantified with MMSE.[89]
Conclusions
Neurodegenerative diseases are devastating conditions with insidious and relentless progression. There is a need for early detection of diseases prior to severe symptom onset.[15][90] Immunohistochemical studies have demonstrated that NDDs frequently involve the neural retina, resulting in alterations of architecture which can be readily observed using OCT technology. Although other neuroimaging modalities are currently being explored, including PET and SPECT, many are cumbersome, expensive and invasive. OCT is relatively quick and inexpensive, and completely non-invasive, and may prove to be an appealing adjunct or alternative for screening and monitoring of NDDs.
References
- ↑ Soto C, Estrada LD. Protein misfolding and neurodegeneration. Archives of neurology. Feb 2008;65(2):184-189.
- ↑ 2.0 2.1 2.2 2.3 Kromer R, Serbecic N, Hausner L, Froelich L, Aboul-Enein F, Beutelspacher SC. Detection of Retinal Nerve Fiber Layer Defects in Alzheimer's Disease Using SD-OCT. Frontiers in psychiatry. 2014;5:22.
- ↑ 3.0 3.1 3.2 3.3 Blanks JC, Schmidt SY, Torigoe Y, Porrello KV, Hinton DR, Blanks RH. Retinal pathology in Alzheimer's disease. II. Regional neuron loss and glial changes in GCL. Neurobiology of aging. May-Jun 1996;17(3):385-395.
- ↑ 4.0 4.1 4.2 4.3 Blanks JC, Torigoe Y, Hinton DR, Blanks RH. Retinal pathology in Alzheimer's disease. I. Ganglion cell loss in foveal/parafoveal retina. Neurobiology of aging. May-Jun 1996;17(3):377-384.
- ↑ 5.0 5.1 5.2 Hinton DR, Sadun AA, Blanks JC, Miller CA. Optic-nerve degeneration in Alzheimer's disease. The New England journal of medicine. Aug 21 1986;315(8):485-487.
- ↑ 6.0 6.1 Harnois C, Di Paolo T. Decreased dopamine in the retinas of patients with Parkinson's disease. Investigative ophthalmology & visual science. Nov 1990;31(11):2473-2475.
- ↑ 7.0 7.1 Fawzi AA, Simonett JM, Purta P, et al. Clinicopathologic report of ocular involvement in ALS patients with C9orf72 mutation. Amyotrophic lateral sclerosis & frontotemporal degeneration. Dec 2014;15(7-8):569-580.
- ↑ 8.0 8.1 Volpe NJ, Simonett J, Fawzi AA, Siddique T. Ophthalmic Manifestations of Amyotrophic Lateral Sclerosis (An American Ophthalmological Society Thesis). Transactions of the American Ophthalmological Society. 2015;113:T12-11-15.
- ↑ Huang D, Swanson EA, Lin CP, et al. Optical coherence tomography. Science (New York, N.Y.). Nov 22 1991;254(5035):1178-1181.
- ↑ Tsokolas G, Tsaousis KT, Diakonis VF, Matsou A, Tyradellis S. Optical Coherence Tomography Angiography in Neurodegenerative Diseases: A Review. Eye Brain. 2020;12:73-87. Published 2020 Jul 14. doi:10.2147/EB.S193026
- ↑ Georgios Tsokolas, Konstantinos T Tsaousis, Vasilios F Diakonis, Artemis Matsou & Straton Tyradellis (2020) Optical Coherence Tomography Angiography in Neurodegenerative Diseases: A Review, Eye and Brain, 12:, 73-87, DOI: 10.2147/EB.S193026
- ↑ Herbert LE, Weuve J, Scherr PA, Evans DA. Alzheimer disease in the United States (2010-2050) estimated using 2010 census. Neurology. 2013 May 7 2013;80(19):1778-1783.
- ↑ 13.0 13.1 Daviglus ML, Bell CC, Berrettini W, et al. NIH state-of-the-science conference statement: Preventing Alzheimer's disease and cognitive decline. NIH consensus and state-of-the-science statements. Apr 28 2010;27(4):1-30.
- ↑ 14.0 14.1 Ballard C, Gauthier S, Corbett A, Brayne C, Aarsland D, Jones E. Alzheimer's disease. Lancet (London, England). Mar 19 2011;377(9770):1019-1031.
- ↑ 15.0 15.1 Ikram MK, Cheung CY, Wong TY, Chen CP. Retinal pathology as biomarker for cognitive impairment and Alzheimer's disease. Journal of neurology, neurosurgery, and psychiatry. Sep 2012;83(9):917-922.
- ↑ Trick GL, Trick LR, Morris P, Wolf M. Visual field loss in senile dementia of the Alzheimer's type. Neurology. 1995;45(1):68-74. doi:10.1212/wnl.45.1.68
- ↑ Mendez MF, Tomsak RL, Remler B. Disorders of the visual system in Alzheimer's disease. Journal of clinical neuro-ophthalmology. Mar 1990;10(1):62-69.
- ↑ 18.0 18.1 Guo L, Duggan J, Cordeiro MF. Alzheimer's disease and retinal neurodegeneration. Current Alzheimer research. Feb 2010;7(1):3-14.
- ↑ Molitor RJ, Ko PC, Ally BA. Eye movements in Alzheimer's disease. J Alzheimers Dis. 2015;44(1):1-12.
- ↑ Katz B, Rimmer S, Iragui V, Katzman R. Abnormal pattern electroretinogram in Alzheimer's disease: evidence for retinal ganglion cell degeneration? Annals of neurology. Aug 1989;26(2):221-225.
- ↑ Trick GL, Barris MC, Bickler-Bluth M. Abnormal pattern electroretinograms in patients with senile dementia of the Alzheimer type. Annals of neurology. Aug 1989;26(2):226-231.
- ↑ Sadun AA, Bassi CJ. The visual system in Alzheimer's disease. Research publications - Association for Research in Nervous and Mental Disease. 1990;67:331-347.
- ↑ 23.0 23.1 Lee MJ, Abraham AG, Swenor BK, Sharrett AR, Ramulu PY. Application of Optical Coherence Tomography in the Detection and Classification of Cognitive Decline. J Curr Glaucoma Pract. 2018;12(1):10-18. doi:10.5005/jp-journals-10028-1238
- ↑ 24.0 24.1 24.2 24.3 Parisi V, Restuccia R, Fattapposta F, Mina C, Bucci MG, Pierelli F. Morphological and functional retinal impairment in Alzheimer's disease patients. Clinical neurophysiology : official journal of the International Federation of Clinical Neurophysiology. Oct 2001;112(10):1860-1867.
- ↑ Iseri PK, Altinas O, Tokay T, Yuksel N. Relationship between cognitive impairment and retinal morphological and visual functional abnormalities in Alzheimer disease. Journal of neuro-ophthalmology : the official journal of the North American Neuro-Ophthalmology Society. Mar 2006;26(1):18-24.
- ↑ 26.0 26.1 26.2 Paquet C, Boissonnot M, Roger F, Dighiero P, Gil R, Hugon J. Abnormal retinal thickness in patients with mild cognitive impairment and Alzheimer's disease. Neuroscience letters. Jun 13 2007;420(2):97-99.
- ↑ Chan VTT, Sun Z, Tang S, et al. Spectral-Domain OCT Measurements in Alzheimer's Disease: A Systematic Review and Meta-analysis. Ophthalmology. 2019;126(4):497-510. doi:10.1016/j.ophtha.2018.08.009
- ↑ Loh EH, Ong YT, Venketasubramanian N, et al. Repeatability and Reproducibility of Retinal Neuronal and Axonal Measures on Spectral-Domain Optical Coherence Tomography in Patients with Cognitive Impairment. Front Neurol. 2017;8:359. Published 2017 Aug 15. doi:10.3389/fneur.2017.00359
- ↑ Salobrar-García E, de Hoz R, Ramírez AI, et al. Changes in visual function and retinal structure in the progression of Alzheimer's disease. PLoS One. 2019;14(8):e0220535. Published 2019 Aug 15. doi:10.1371/journal.pone.0220535
- ↑ La Morgia C, Ross-Cisneros FN, Koronyo Y, Hannibal J, Gallassi R, Cantalupo G, et al. Melanopsin retinal ganglion cell loss in Alzheimer disease. Ann Neurol [Internet]. 2016 Jan [cited 2019 Aug 14];79(1):90–109. Available from: http://www.ncbi.nlm.nih.gov/pubmed/26505992
- ↑ 31.0 31.1 Kirbas S, Turkyilmaz K, Tufekci A, Durmus M. Retinal nerve fiber layer thickness in Parkinson disease. Journal of neuro-ophthalmology : the official journal of the North American Neuro-Ophthalmology Society. Mar 2013;33(1):62-65.
- ↑ 32.0 32.1 Altintas O, Iseri P, Ozkan B, Caglar Y. Correlation between retinal morphological and functional findings and clinical severity in Parkinson's disease. Documenta ophthalmologica. Advances in ophthalmology. Mar 2008;116(2):137-146.
- ↑ Armstrong RA. Visual Dysfunction in Parkinson's Disease. Int Rev Neurobiol. 2017;134:921-946. doi: 10.1016/bs.irn.2017.04.007. Epub 2017 May 31. PMID: 28805589.
- ↑ Garcia-Martin E, Satue M, Otin S, et al. Retina measurements for diagnosis of Parkinson disease. Retina (Philadelphia, Pa.). May 2014;34(5):971-980.
- ↑ Witkovsky P. Dopamine and retinal function. Documenta ophthalmologica. Advances in ophthalmology. Jan 2004;108(1):17-40.
- ↑ Djamgoz MB, Hankins MW, Hirano J, Archer SN. Neurobiology of retinal dopamine in relation to degenerative states of the tissue. Vision research. Dec 1997;37(24):3509-3529.
- ↑ Brandies R, Yehuda S. The possible role of retinal dopaminergic system in visual performance. Neuroscience and biobehavioral reviews. 2008;32(4):611-656.
- ↑ Inzelberg R, Ramirez JA, Nisipeanu P, Ophir A. Retinal nerve fiber layer thinning in Parkinson disease. Vision research. Nov 2004;44(24):2793-2797.
- ↑ La Morgia C, Barboni P, Rizzo G, et al. Loss of temporal retinal nerve fibers in Parkinson disease: a mitochondrial pattern? European journal of neurology : the official journal of the European Federation of Neurological Societies. Jan 2013;20(1):198-201.
- ↑ 40.0 40.1 Garcia-Martin E, Larrosa JM, Polo V, et al. Distribution of retinal layer atrophy in patients with Parkinson disease and association with disease severity and duration. American journal of ophthalmology. Feb 2014;157(2):470-478 e472.
- ↑ Jimenez B, Ascaso FJ, Cristobal JA, Lopez del Val J. Development of a prediction formula of Parkinson disease severity by optical coherence tomography. Movement disorders : official journal of the Movement Disorder Society. Jan 2014;29(1):68-74.
- ↑ Aaker GD, Myung JS, Ehrlich JR, Mohammed M, Henchcliffe C, Kiss S. Detection of retinal changes in Parkinson's disease with spectral-domain optical coherence tomography. Clinical ophthalmology (Auckland, N.Z.). 2010;4:1427-1432.
- ↑ Archibald NK, Clarke MP, Mosimann UP, Burn DJ. Retinal thickness in Parkinson's disease. Parkinsonism & related disorders. Jul 2011;17(6):431-436.
- ↑ Yu JG, Feng YF, Xiang Y, et al. Retinal nerve fiber layer thickness changes in Parkinson disease: a meta-analysis. PloS one. 2014;9(1):e85718.
- ↑ Garcia-Martin E, Rodriguez-Mena D, Satue M, et al. Electrophysiology and optical coherence tomography to evaluate Parkinson disease severity. Investigative ophthalmology & visual science. Feb 2014;55(2):696-705.
- ↑ Shrier EM, Adam CR, Spund B, Glazman S, Bodis-Wollner I. Interocular asymmetry of foveal thickness in Parkinson disease. Journal of ophthalmology. 2012;2012:728457.
- ↑ Cubo E, Tedejo RP, Rodriguez Mendez V, Lopez Pena MJ, Trejo Gabriel YGJM. Retina thickness in Parkinson's disease and essential tremor. Movement disorders : official journal of the Movement Disorder Society. Oct 30 2010;25(14):2461-2462.
- ↑ 48.0 48.1 Spund B, Ding Y, Liu T, et al. Remodeling of the fovea in Parkinson disease. Journal of neural transmission (Vienna, Austria : 1996). May 2013;120(5):745-753.
- ↑ Ding Y, Spund B, Glazman S, et al. Application of an OCT data-based mathematical model of the foveal pit in Parkinson disease. Journal of neural transmission (Vienna, Austria : 1996). Apr 20 2014.
- ↑ 50.0 50.1 Albrecht P, Muller AK, Sudmeyer M, et al. Optical coherence tomography in parkinsonian syndromes. PloS one. 2012;7(4):e34891.
- ↑ 51.0 51.1 51.2 51.3 51.4 Schneider M, Muller HP, Lauda F, et al. Retinal single-layer analysis in Parkinsonian syndromes: an optical coherence tomography study. Journal of neural transmission (Vienna, Austria : 1996). Jan 2014;121(1):41-47.
- ↑ 52.0 52.1 Adam CR, Shrier E, Ding Y, Glazman S, Bodis-Wollner I. Correlation of inner retinal thickness evaluated by spectral-domain optical coherence tomography and contrast sensitivity in Parkinson disease. Journal of neuro-ophthalmology : the official journal of the North American Neuro-Ophthalmology Society. Jun 2013;33(2):137-142.
- ↑ Hajee ME, March WF, Lazzaro DR, et al. Inner retinal layer thinning in Parkinson disease. Archives of ophthalmology. Jun 2009;127(6):737-741.
- ↑ Satue M, Obis J, Alarcia R, Orduna E, Rodrigo MJ, Vilades E, et al. Retinal and Choroidal Changes in Patients with Parkinson’s Disease Detected by Swept-Source Optical Coherence Tomography. Curr Eye Res [Internet]. 2018 Jan 2 [cited 2019 Aug 14];43(1):109–15. Available from: https://www.tandfonline.com/doi/full/10.1080/02713683.2017.1370116
- ↑ Zou J, Liu K, Li F, Xu Y, Shen L, Xu H. Combination of optical coherence tomography (OCT) and OCT angiography increases diagnostic efficacy of Parkinson's disease. Quant Imaging Med Surg. 2020 Oct;10(10):1930-1939. doi: 10.21037/qims-20-460. PMID: 33014726; PMCID: PMC7495313.
- ↑ Litvan I, Mangone CA, McKee A, et al. Natural history of progressive supranuclear palsy (Steele-Richardson-Olszewski syndrome) and clinical predictors of survival: a clinicopathological study. Journal of neurology, neurosurgery, and psychiatry. Jun 1996;60(6):615-620.
- ↑ Jellinger KA, Seppi K, Wenning GK. Grading of neuropathology in multiple system atrophy: proposal for a novel scale. Movement disorders : official journal of the Movement Disorder Society. Aug 2005;20 Suppl 12:S29-36.
- ↑ Stemplewitz B, Kromer R, Vettorazzi E, Hidding U, Frings A, Buhmann C. Retinal degeneration in progressive supranuclear palsy measured by optical coherence tomography and scanning laser polarimetry. Sci Rep [Internet]. 2017 Dec 13 [cited 2019 Aug 14];7(1):5357. Available from: http://www.ncbi.nlm.nih.gov/pubmed/28706282
- ↑ Gulmez Sevim D, Unlu M, Gultekin M, Karaca C, Mirza M, Mirza GE. Evaluation of Retinal Changes in Progressive Supranuclear Palsy and Parkinson Disease. J Neuroophthalmol [Internet]. 2018 Jun [cited 2019 Aug 14];38(2):151–5. Available from: http://www.ncbi.nlm.nih.gov/pubmed/29240574
- ↑ 60.0 60.1 Wijesekera LC, Leigh PN. Amyotrophic lateral sclerosis. Orphanet journal of rare diseases. 2009;4:3.
- ↑ Fincham RW, Vanallen MW. Sensory Nerve Conduction in Amyotrophic Lateral Sclerosis. Neurology. Jan 1964;14:31-33.
- ↑ Feller TG, Jones RE, Netsky MG. Amyotrophic lateral sclerosis and sensory changes. Virginia medical monthly. Jun 1966;93(6):328-335.
- ↑ 63.0 63.1 Isaacs JD, Dean AF, Shaw CE, Al-Chalabi A, Mills KR, Leigh PN. Amyotrophic lateral sclerosis with sensory neuropathy: part of a multisystem disorder? Journal of neurology, neurosurgery, and psychiatry. Jul 2007;78(7):750-753.
- ↑ 64.0 64.1 64.2 Hammad M, Silva A, Glass J, Sladky JT, Benatar M. Clinical, electrophysiologic, and pathologic evidence for sensory abnormalities in ALS. Neurology. Dec 11 2007;69(24):2236-2242.
- ↑ Pugdahl K, Fuglsang-Frederiksen A, de Carvalho M, et al. Generalised sensory system abnormalities in amyotrophic lateral sclerosis: a European multicentre study. Journal of neurology, neurosurgery, and psychiatry. Jul 2007;78(7):746-749.
- ↑ Gregory R, Mills K, Donaghy M. Progressive sensory nerve dysfunction in amyotrophic lateral sclerosis: a prospective clinical and neurophysiological study. Journal of neurology. May 1993;240(5):309-314.
- ↑ Grosskreutz J, Kaufmann J, Fradrich J, Dengler R, Heinze HJ, Peschel T. Widespread sensorimotor and frontal cortical atrophy in Amyotrophic Lateral Sclerosis. BMC neurology. 2006;6:17.
- ↑ Moss HE, McCluskey L, Elman L, et al. Cross-sectional evaluation of clinical neuro-ophthalmic abnormalities in an amyotrophic lateral sclerosis population. Journal of the neurological sciences. Mar 15 2012;314(1-2):97-101.
- ↑ 69.0 69.1 Roth NM, Saidha S, Zimmermann H, et al. Optical coherence tomography does not support optic nerve involvement in amyotrophic lateral sclerosis. European journal of neurology : the official journal of the European Federation of Neurological Societies. Aug 2013;20(8):1170-1176.
- ↑ 70.0 70.1 Mukherjee N KA, Bedlack R, Tseng H. Imaging amyotrophic lateral sclerosis (ALS) neurodegeneration through the eye. ARVO; 2014, 2014; Orlando, Florida.
- ↑ Simonett J CJ, Siddique N, Armstrong JL, Fawzi AA, Siddique T, Volpe NJ. Ocular Manifestations and Optic Nerve Changes in Patients with Amyotrophic Lateral Sclerosis (ALS). ARVO; 2013.
- ↑ Mukherjee N, McBurney-Lin S, Kuo A, Bedlack R, Tseng H. Retinal thinning in amyotrophic lateral sclerosis patients without ophthalmic disease. Bhattacharya S, editor. PLoS One [Internet]. 2017 Sep 25 [cited 2019 Aug 14];12(9):e0185242. Available from: http://www.ncbi.nlm.nih.gov/pubmed/28945811
- ↑ Mittag TW, Bayer AU, La VM. Light-induced retinal damage in mice carrying a mutated SOD I gene. Experimental eye research. Dec 1999;69(6):677-683.
- ↑ Hoglund K, Salter H. Molecular biomarkers of neurodegeneration. Expert review of molecular diagnostics. Nov 2013;13(8):845-861.
- ↑ Risacher SL, Saykin AJ. Neuroimaging biomarkers of neurodegenerative diseases and dementia. Seminars in neurology. Sep 2013;33(4):386-416.
- ↑ McColgan P, Tabrizi SJ. Huntington's disease: a clinical review. Eur J Neurol. 2018 Jan;25(1):24-34. doi: 10.1111/ene.13413. Epub 2017 Sep 22. PMID: 28817209.
- ↑ Imarisio S, Carmichael J, Korolchuk V, et al. Huntington’s disease: from pathology and genetics to potential therapies. Biochemical Journal. 2008;412(2):191-209. doi:10.1042/BJ20071619
- ↑ Avanzini G, Girotti F, Caraceni T, Spreafico R. Oculomotor disorders in Huntington’s chorea. Journal of Neurology, Neurosurgery & Psychiatry. 1979;42(7):581-589. doi:10.1136/jnnp.42.7.581
- ↑ Lasker AG, Zee DS. Ocular motor abnormalities in Huntington’s disease. Vision Research. 1997;37(24):3639-3645. doi:10.1016/S0042-6989(96)00169-1
- ↑ Klöppel S, Draganski B, Golding CV, Chu C, Nagy Z, Cook PA, Hicks SL, Kennard C, Alexander DC, Parker GJ, Tabrizi SJ, Frackowiak RS. White matter connections reflect changes in voluntary-guided saccades in pre-symptomatic Huntington's disease. Brain. 2008 Jan;131(Pt 1):196-204. doi: 10.1093/brain/awm275.
- ↑ Kersten HM, Danesh-Meyer HV, Kilfoyle DH, Roxburgh RH. Optical coherence tomography findings in Huntington’s disease: a potential biomarker of disease progression. J Neurol. 2015;262(11):2457-2465. doi:10.1007/s00415-015-7869-2
- ↑ Gatto E, Parisi V, Persi G, et al. Optical coherence tomography (OCT) study in Argentinean Huntington’s disease patients. International Journal of Neuroscience. 2018;128(12):1157-1162. doi:10.1080/00207454.2018.1489807
- ↑ Andrade C, Beato J, Monteiro A, et al. Spectral-Domain Optical Coherence Tomography as a Potential Biomarker in Huntington’s Disease: OCT in Huntington’s Disease. Mov Disord. 2016;31(3):377-383. doi:10.1002/mds.26486
- ↑ 84.0 84.1 Pan XD, Chen XC. Clinic, neuropathology and molecular genetics of frontotemporal dementia: a mini-review. Transl Neurodegener. 2013;2(1):8. Published 2013 Apr 19. doi:10.1186/2047-9158-2-8
- ↑ Ratnavalli E, Brayne C, Dawson K, Hodges JR. The prevalence of frontotemporal dementia. Neurology. 2002;58(11):1615-1621. doi:10.1212/wnl.58.11.1615
- ↑ Mercy L, Hodges JR, Dawson K, Barker RA, Brayne C. Incidence of early-onset dementias in Cambridgeshire, United Kingdom. Neurology. 2008;71(19):1496-1499. doi:10.1212/01.wnl.0000334277.16896.fa
- ↑ Olney NT, Spina S, Miller BL. Frontotemporal Dementia. Neurol Clin. 2017;35(2):339-374. doi:10.1016/j.ncl.2017.01.008
- ↑ Kim BJ, Irwin DJ, Song D, et al. Optical coherence tomography identifies outer retina thinning in frontotemporal degeneration. Neurology. 2017;89(15):1604-1611. doi:10.1212/WNL.0000000000004500
- ↑ Kim BJ, Grossman M, Song D, et al. Persistent and Progressive Outer Retina Thinning in Frontotemporal Degeneration. Front Neurosci. 2019;13:298. doi:10.3389/fnins.2019.00298
- ↑ Jia Q, Deng Y, Qing H. Potential Therapeutic Strategies for Alzheimer's Disease Targeting or Beyond -Amyloid: Insights from Clinical Trials. BioMed research international. 2014;2014:837157.